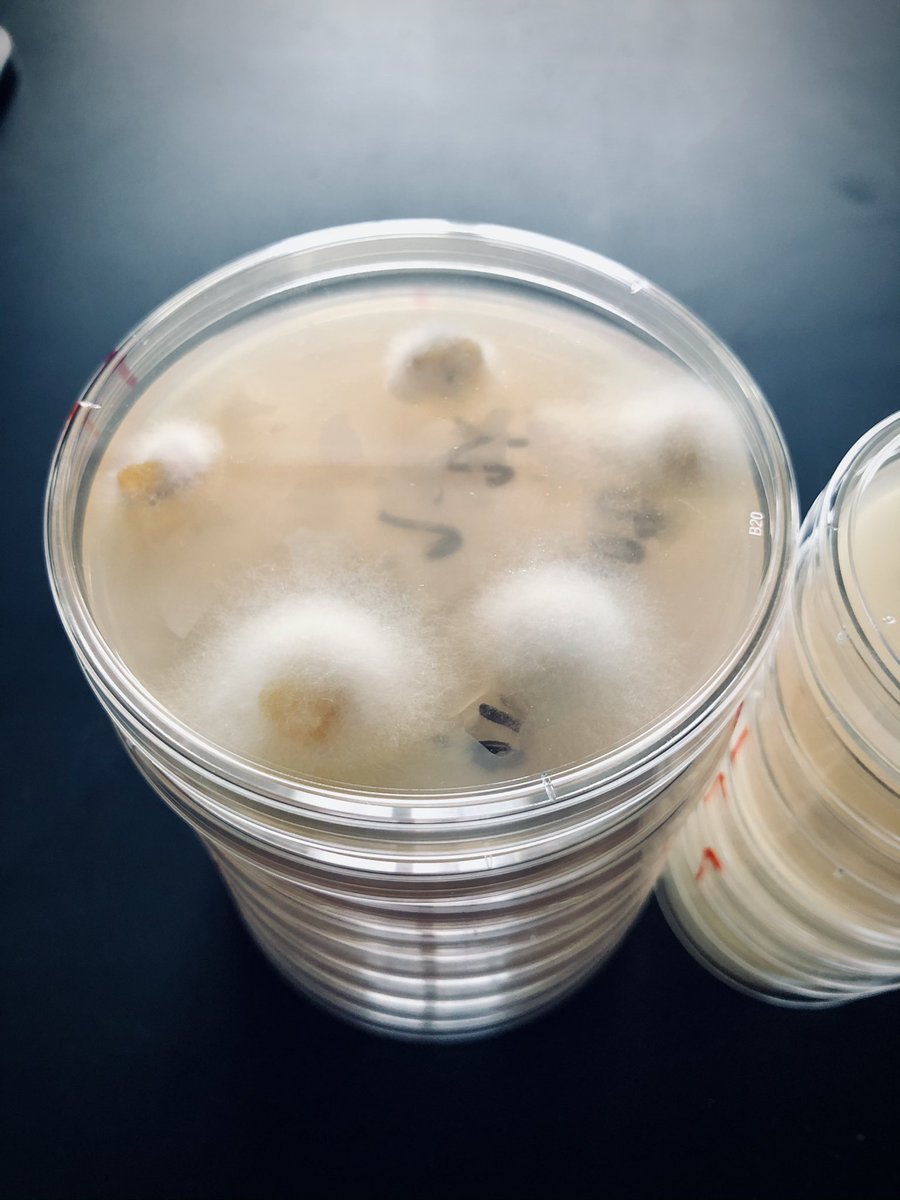
Zachariah Hansen tweet media

Tim Siegenthaler
19 posts

Tim Siegenthaler
@TimSeeg
The Ohio State University- Department of Plant Pathology - Graduate Student (PhD) - USDA Testen Lab - He/him
Canton, OH Katılım Temmuz 2019
120 Takip Edilen129 Takipçiler

Check out some of the P. capsici population genetics research I did while working with @UTSpecialtyCrop during my time as a MS student in @epp_tn.
Zachariah Hansen@PlantDiseaseGuy
"Population structure of Phytophthora capsici in the state of Tennessee" now available - open access - from Mycological Progress. Check it out! Well done @epp_tn grad @TimSeeg, & thanks Dr. Kurt Lamour for the huge help on genotyping. doi.org/10.1007/s11557…
English

@UTSpecialtyCrop @UTAgResearch @utextension @epp_tn It still amazes me how beautiful that research site is
English

Harvested our burley tobacco black shank trial today. Results should help growers manage this disease. Pro tip: let the pros (not me) handle the knives & spikes. Thankful for the @UTAgResearch crew at the Northeast TN REC for their knowledge & hard work. @utextension @epp_tn




English

@UTSpecialtyCrop @OSUPlantPath @epp_tn @roofusever Thanks a lot Zach, I have really enjoy all we have done together.
English

Congrats Tim! Can’t wait to see what you do during your PhD. @OSUPlantPath is getting a good one! @epp_tn @TimSeeg @roofusever

English
Tim Siegenthaler retweetledi

While I nodded, nearly napping,
suddenly there came a tapping,
As of some hemp rust gently rapping,
rapping at my humid chamber door
#HappyHalloween
GIF
Maryville, TN 🇺🇸 English
Tim Siegenthaler retweetledi
Tim Siegenthaler retweetledi

Gotta love it when inoculum cooperates for an experiment. Looked like some substantial differences in disease susceptibility among dark tobacco varieties. More to come.
#angularleafspot #pseudomonas #tobacco
@epp_tn @utextension @UTAgResearch



English

Thanks @plantdisease for putting on a great convention. Could not have asked for a better first APS National. Can't wait for next time so we continue to share our collective knowledge, make and build better relationships #PlantHealth2019
English
Tim Siegenthaler retweetledi
Tim Siegenthaler retweetledi
Tim Siegenthaler retweetledi

@TimSeeg presenting his M.S. work on population structure and fungicide sensitivity of Phytophthora capsici in Tennessee. #popgen @epp_tn @UTIAg @utextension @UTSpecialtyCrop #PlantHealth2019

English